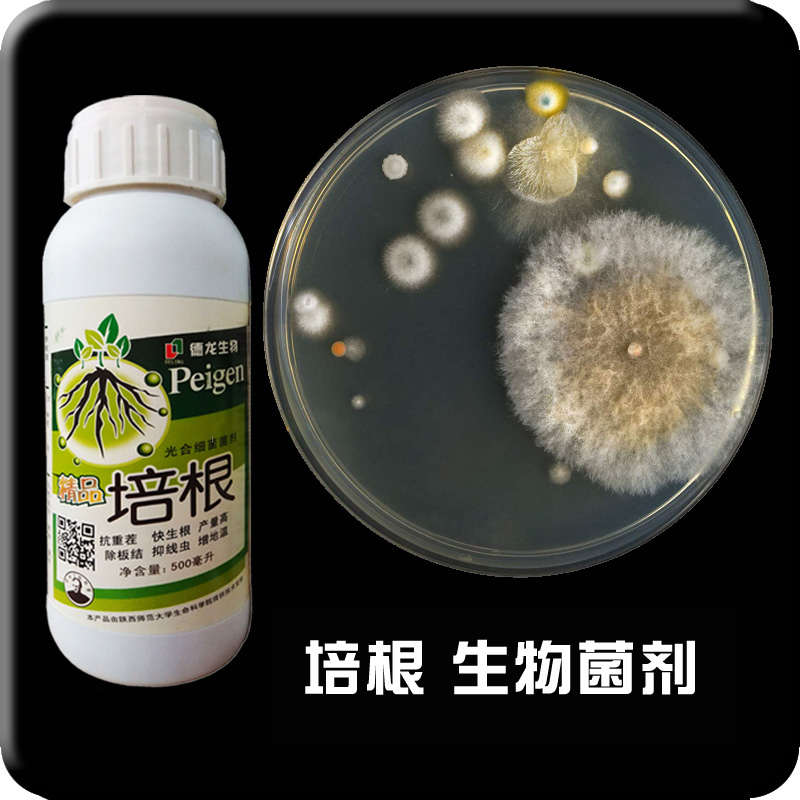

该商品,折扣价79.60元,最终促销价为75.62元,由浙江 温州(水族雨花石)卖家销售,年销售量为0件。
当前商品数据为机器人实时监控全网优惠信息并自动发布,优惠信息具有一定时效性,请友友们注意购买。若发现已售罄过期,请点击“举报”告知小T机器人~
相关推荐
猜你喜欢
相关分类
个人生活护理
环保生活
竹制品
蓄电池
画框
檀香
钥匙刀
锂电池
镜子
防蚊液
雨衣
面盆
鱼饵
充电电池
衣物柔顺剂
蟑螂药
蚊香
洗洁精
洗衣液
洗衣皂
洗衣粉
浴帘
浴盐
渔具
温湿度计
洁厕剂
毛球修剪器
整理箱
晴雨伞
晾衣架
暖手器
望远镜
杀虫剂
梳子
棉签
灭蚊器
灭蚊灯
种子
空气清新剂
红外测温仪
空气检测仪
纸巾抽纸
缝纫线
置物架
脂肪测量仪
禽药
睡袋
熏香
熨衣板
牙签
电子称
电热水袋
电蚊拍
电蚊香
真空压缩袋
排插
拖把
偏光镜
帐篷
干电池
应急包
手电筒
扑克牌
打火机
头盔
健眼仪
3D眼镜
兽药
取暖贴
台秤
垃圾桶
塑料膜
塑料袋
电推剪
理发器
电动牙刷
吸管杯
扫把
酒具
开水器
眉眼
护眼
毛巾浴巾
沐浴露
漱口水
冲牙器
脱毛器
脱毛膏
化妆棉
保温杯
玻璃杯
水杯
日用陶瓷
养生壶
牙膏牙刷
热水瓶
晾衣机
水景摆件园艺
耳塞
清洁剂
口气清新剂
成人纸尿裤
家居卖场
皮革护理
环保产品
日用品
家庭用品
甲醛清除剂
磨刀石
消毒仪
老花镜
花瓶
抽纸
退烧贴
洗鼻器
鱼线
台历
剪刀
打气筒
纽扣电池
瑜伽铺巾
围棋
荧光笔
跳棋
荧光棒
暖宝宝
雨伞
热水袋
拐杖
收纳箱
桌旗
衣架
肥皂
卫生纸
货架
招财猫
护垫
水晶球
家居日用
围裙
收纳盒
收纳柜
指甲钳
贴膜
电池充电器
灭蝇灯
日化品
太空杯
水果刀
玻璃器皿
花器
甲醛治理
室内空气治理
家居香薰
可降解环保袋
除甲醛
鼻烟壶
鼻毛修剪器
黑胶钓鱼伞
黑胶太阳伞
黑胶伞
卡纸
厕纸盒
墙上置物架
护目镜
母婴店
洗头椅
洗头床
浴室置物架
烫衣板
鸡蛋盒
鸡蛋杯
鸡毛掸子
纸巾
鱼鳞刨
魔术扑克
魔力胶
UV镜
高尔夫伞
三角巾
高压打气筒
驱鼠器
驱蚊花露水
驱蚊灯
驱蚊液
驱蚊手环
驱蚊器
驱虫药
马桶贴
马桶套
马桶垫纸
马桶垫
香薰蜡烛
香薰炉
香薰灯
香薰
香炉
香水瓶
香柏木桶
饺子托盘
餐盘纸
餐桌布
餐桌垫
餐巾纸
餐厅灭蚊灯
餐具筒
餐具笼
餐具架
食品袋
保温壶
飞行棋
保温水壶
保温瓶
飞机盒
风水罗盘
儿童保温壶
婴儿保温杯
韩式烤盘
鞋套机
面部刮痧板
面巾纸
靠山石
静音钟
办公杯
卷纸
卷筒纸
雨衣套装
雨花石
雨具
雨伞架
隔音耳塞
隔热碗
隔热杯
隐形眼镜盒
随手杯
陶瓷酒壶
陶瓷茶叶罐
陶瓷花盆
陶瓷花瓶
陶瓷罐
双人睡袋
陶瓷摆件
陶瓷密封罐
陶壶
陶器
反光伞
除霉剂
反光雨衣
除螨剂
除菌剂
除臭剂
除甲醛活性炭
除甲醛产品
除湿剂
除油剂
除尘掸子
除尘垫
除垢粉
除垢剂
除味活性炭包
除味活性炭
陆战棋
阻燃垃圾桶
阳光罐
防风伞
防锈剂
防近视眼镜
防辐射眼镜
塑料家居
防蚊水
防蚊手环
防蓝光老花镜
防蓝光眼镜
防蓝光护目镜
防紫外线口罩
防紫外线伞
塑料箱
防烫碗
防烫杯
防潮罐
防水洗漱包
防水围裙
防晒雨伞
防晒太阳伞
防尘罩
防尘网
防噪音耳塞
闻香杯
太阳伞
成人浴巾
可折叠晾衣架
长款雨衣
长嘴壶
挂钩
锡箔纸
搓澡巾
银胶伞
铝箔餐盒
铝箔纸
棉柔巾
钛保温杯
滤水杯
金属置物架
漱口杯
重油污清洁剂
醒酒器
酒精炉
遮光眼罩
透明雨衣
进口保温杯
运动水杯
过滤茶杯
过滤水壶
皂粉
跳蚤药
直柄雨伞
超声波驱鼠器
超声波牙刷
空调清洗剂
竹纤维纸巾
生活用纸
感应垃圾桶
擦手纸
抹布
墙面收纳架
不锈钢保温壶
餐具洗涤剂
洗衣凝珠
漂白剂
无磷洗衣粉
烫熨板
分茶器
透明皂
不锈钢水果刀
遮阳伞
保温箱
厨房纸巾
泡脚木桶
纸业
玻璃养生壶
洁厕灵
洗衣露
天然皂粉
洗碗液
收纳袋
家务手套
衣物消毒液
留香珠
洁面巾
衣物护理剂
漂白粉
除味剂
线香
免洗拖把
毛刷
电烤蚊香片
固体芳香剂
漂白水
湿厕纸
杀虫气雾剂
清洁手套
家用毛刷
暖手宝
洗洁剂
浓缩洗衣液
泡沫洗手液
裁缝剪刀
折叠熨衣板
玻璃保温壶
地板清洁剂
盘香
静电除尘掸
全自动拖把
旋转拖把
衣物清洗剂
玻璃制品
洗碗粉
抽取式面巾纸
危废间
危废暂存间
危废间集装箱
推荐文章
精选好价
充气月球气模九大行星宇航天员登月布置学校运动会美陈装饰火箭
471.00 元
多管路气排分气块气路排直通多通气管快速接带安装孔气路分配器铝
45.20 元
垃圾桶家用2023新款有盖卫生间厕所夹缝专用客厅按压式大容量带盖
114.10 元
德龙培根复合微生物菌肥菌剂生根壮苗剂蔬菜植物肥料抗重茬菌通用
68.10 元

冀ICP备2025101513号
冀ICP备2025101513号